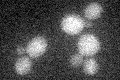
YHR216W
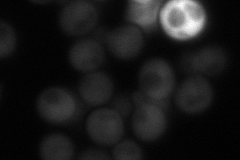
YHR216W
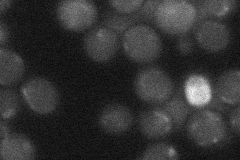
YHR216W
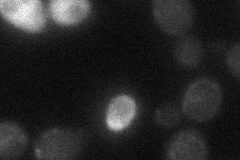
YHR216W

View description
Inosine monophosphate dehydrogenase, catalyzes the rate-limiting step in GTP biosynthesis, expression is induced by mycophenolic acid resulting in resistance to the drug, expression is repressed by nutrient limitatio
Localization:
Intensity:
Fold change:
Significance:
-
C’ GFP library in SD
below threshold15.96 -
N' NOP1pr-GFP in SD
cytosol53.9397 -
N' TEF2pr-mCherry in SD

cytosol38.2471 -
N' NATIVEpr-GFP in SD
below threshold18.9577 -
N' TEF2pr-VC and Cyto-VN in SD
below threshold22.2637 -
C’ GFP library in SD+DTT

cytosol18.161.13No -
C’ GFP library in SD+H2O2

cytosol16.131.01No -
C’ GFP library in Starvation Media

cytosol16.321.02No -
C’ GFP library on the background of Pup2-DaMP

below threshold -
C’ GFP library on the background of CCT mutant

below threshold16.93951.0606No
